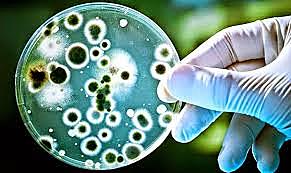
Clasificacion de las enfermedades infecciosas

Historia de los conceptos de causa y enfermedad: paralelismo entre la Medicina y la Fitopatología
By bryanalex
-
La religión era muy importante en la curación de enfermedades en los seres humanos ya sea con otros nombre como curanderos, hechiceros; siempre la han utilizado, en la agricultura utilizaban ritos, sacrificios animales, ofrendas, conjuros etc... para alejar las enfermedades de las plantas.
Tenían libros con conjuros hechicerías y Dioses que eran los protectores de la agricultura. -
La superstición, la magia y la hechicería la utilizaban médicos, curanderos, encantadores, sacerdotes, chamanes, igualmente para las plantas se les realizaban rituales o se tenían supersticiones de ellas que son las que traían las enfermedades
-
La teoría humoral rompió a creencia de la influencia divina en las enfermedades.
se crearon
la medicina se utilizaba según elementos de la naturaleza como el fuego, aire, tierra, espacio. y interacción de los sólidos y líquidos que si había alguna inconsistencia se podía crear una enfermedad por lo cual ya se empezaban a dar cuenta de que se podía determinar las enfermedades de forma física visible y resolverlas así mismo. -
Los miasmas eran exhalaciones pútridas y vapores o gases liberados por la materia orgánica vegetal o animal en descomposición.
Se creían que los malos olores eran los responsables de cualquier enfermedad y en la agricultura =se decía que la roya se daba era por los gases de los ríos -
El suizo Isaac-Bénédict Prévost observado al microscopio las esporas del hongo asociado con la caries del trigo, las cuales al ser inoculadas a plántulas sanas, causaron la misma enfermedad.
Demostro que un hongo era el causante de una enfermedad -
Se dice que la luna y los planetas afectan el comportamiento de los humanos y las plantas, creían también que algunos planetas eran causantes de algunas enfermedades fuertes como la peste negra.
Se tenían horóscopos para los cambios lunares los cuales se utilizaban para la siembra y las operaciones que se realizan al transcurso de su desarrollo -
Hipócrates fue posiblemente uno de los primeros médicos en proponer una clasificación de las enfermedades, la cual, al igual que las otras propuestas de la época, fue de naturaleza sintomatológica, aunque con un fuerte componente cosmológico. Desglosó tres categorías: enfermedades de la cabeza, enfermedades de la piel, y enfermedades de la cavidad.
-
Se llego a la conclusión que no era necesario la utilización de laboratorios para saber la enfermedad infecciosa.
Estudios de forma negativa con varias enfermedades dieron incio a la virología
Se descubrió que los hongos eran los que desarrollaban las enfermedades -
Se abrió a una nueva era ya que se enfocó en la observación experimental y abrió el concepto
Investigo la infección urinaria en el hombre y se descubrió la estrategia de microbios en la enfermedad, de este modo descubrieron algunas bacterias que eran causantes de algunas enfermedades. -
segun Charles Bouchard, miembro de la Academia y autor del texto "Los microbios patógenos" de 1892, las "enfermedades infecciosas" pueden ser específicas, no específicas o parasíticas. Las específicas están asociadas con bacterias, hongos o animales como en el caso de la malaria; las no específicas se caracterizan por septicemias e inflamaciones y las parasíticas son causadas por ácaros o por gusanos intestinales